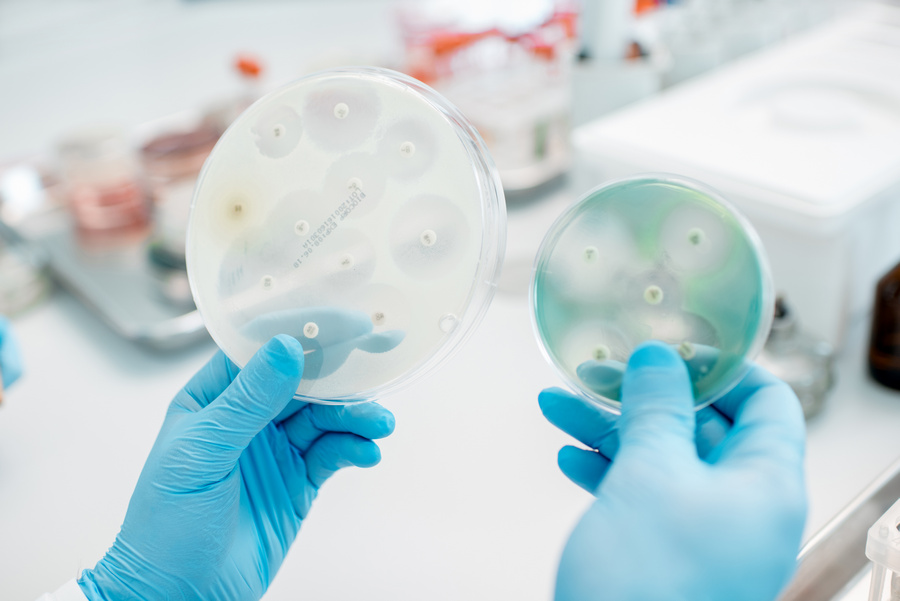
Бактерии с антибиотиками в чашках Петри Бактерии с антибиотиками в чашках Петри

На сегодняшний день российские компании обеспечивают от 50% до 60% от общего объема потребления антибиотиков в стране. Этот объем включает в себя продукцию как локализованных зарубежных, так и российских фармацевтических предприятий. Об этом сообщает ТАСС, ссылаясь на главного внештатного специалиста Минздрава России по клинической микробиологии и антимикробной резистентности, ректора Смоленского государственного медицинского университета Минздрава России, члена-корреспондента РАН Романа Козлова, который выступил на круглом столе, посвященному глобальной проблеме устойчивости микроорганизмов к противомикробным препаратам.
Эксперт отметил, что проблема устойчивости к антибиотикам (антибиотикорезистентность) остается актуальной, она обходится миру примерно в $1 трлн ежегодно, из которых более $400 млпд тратятся на лечение устойчивых бактериальных инфекций, а еще почти $450 млрд — это вызванная ей потеря рабочей силы и снижение производительности труда. Однако, по словам эксперта отсутствие доступа к эффективным и безопасным противомикробным препаратам может привести к большему числу смертей, чем сама устойчивость бактерий к антибиотикам.